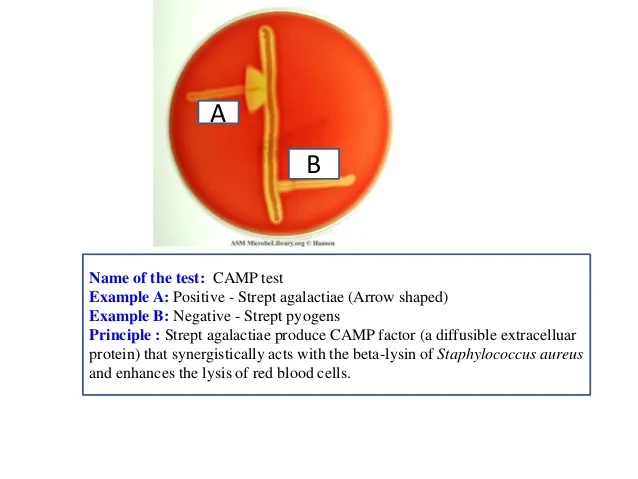
CAMP Test for GBS Identification

Strep/Entero Basics - Cocci Command Central
- Gram-positive cocci, typically in chains or pairs.
- Catalase-negative (differentiates from Staphylococci).
- Classification based on:
- Hemolysis on blood agar:
- α-hemolysis (partial, green; e.g., S. pneumoniae, Viridans streptococci)
- β-hemolysis (complete; e.g., S. pyogenes, S. agalactiae)
- γ-hemolysis (none; e.g., Enterococcus spp., Group D Streptococci)
- Lancefield grouping (A-W): Based on C-carbohydrate antigen in cell wall.
- Hemolysis on blood agar:

⭐ Lancefield classification, developed by Rebecca Lancefield, is based on the C-carbohydrate (cell wall polysaccharide) antigen for most groups.
- Enterococci: Formerly Group D streptococci, now separate genus. PYR-positive, grow in 6.5% NaCl & bile esculin agar. 📌 Enterococci Endure harsh conditions (NaCl, bile).
Group A Strep - Pyogenes PowerPlay
- Virulence: M protein (key!), Streptolysins O/S, Hyaluronidase, Streptokinase, DNAses.
- Suppurative Diseases:
- Pharyngitis, Impetigo, Erysipelas, Cellulitis, Scarlet fever, Necrotizing fasciitis, Streptococcal Toxic Shock Syndrome (STSS).
- 📌 Mnemonic: Pharyngitis, Skin infections, Scarlet fever, Necrotizing fasciitis, Toxic Shock (PSSNT).
- Non-Suppurative Sequelae:
- Rheumatic Fever (RF), Post-Streptococcal Glomerulonephritis (PSGN).
- Diagnosis: Throat culture, Rapid Antigen Detection Test (RADT); ASO titre (↑ for RF/PSGN).
- Treatment: Penicillin (DOC).
⭐ M protein is the major virulence factor of S. pyogenes, inhibiting phagocytosis and implicated in rheumatic heart disease.

Group B Strep & Co. - Beta Brigade
- Streptococcus agalactiae (GBS): Beta-hemolytic, bacitracin-resistant.
- Key cause: Neonatal sepsis, pneumonia, meningitis. 📌 'Baby' for GBS neonates.
- Maternal screening: 36-37 weeks gestation.
- Intrapartum Antibiotic Prophylaxis (IAP) for: previous GBS neonate, GBS bacteriuria, positive screen, or unknown GBS with risk factors (fever ≥38°C, ROM ≥18h, preterm <37w).
- Lab: Hippurate hydrolysis (+).
⭐ Streptococcus agalactiae (GBS) is CAMP test positive, showing synergistic hemolysis with S. aureus.
- Other Beta-hemolytic Strep (e.g., Groups C, G): Can cause pharyngitis, skin infections.
Pneumo & Viridans - Alpha Avengers
-
Alpha-hemolytic streptococci, crucial distinctions.
-
S. pneumoniae (Pneumococcus)
- Gram-positive, lancet-shaped diplococci.
- Polysaccharide capsule (virulence); Quellung reaction positive.
- 📌 MOPS: Meningitis, Otitis media, Pneumonia (rust-colored sputum), Sinusitis.
- Optochin-sensitive, Bile soluble.
-
Viridans Streptococci
- Normal flora (oral, GIT). S. mutans (dental caries), S. sanguinis (SBE).
- 📌 Viridans: MOUTH flora, cause Subacute Bacterial Endocarditis (SBE) on DAMAGED valves.
- Optochin-resistant, Bile insoluble.

⭐ Streptococcus pneumoniae is optochin-sensitive and bile soluble, key for differentiating from Viridans streptococci (optochin-resistant, bile insoluble).
Enterococci - Gut Guardians Gone Rogue
- Formerly Group D Strep; normal gut/GU flora.
- Characteristics:
- Grow in 6.5% NaCl.
- Bile esculin positive (blackens agar).
- PYR positive.
- Species: E. faecalis (common), E. faecium (↑resistance).
- Infections:
- UTIs, endocarditis (esp. post-GIT/GU surgery).
- Intra-abdominal, biliary tract infections.
- 📌 Enterococci hit you in your UTIs, Biliary tract, and Abdomen.
- Resistance:
- Intrinsic: Cephalosporins, Aminoglycosides (low-level).
- Acquired: Vancomycin (VRE) is a major threat.
⭐ Enterococci (e.g., E. faecalis, E. faecium) are notorious for high-level antibiotic resistance, including Vancomycin (VRE).
High‑Yield Points - ⚡ Biggest Takeaways
- S. pneumoniae: Lancet-shaped diplococci, optochin-sensitive, causes lobar pneumonia, meningitis.
- S. pyogenes (GAS): Bacitracin-sensitive, causes pharyngitis, rheumatic fever, PSGN.
- S. agalactiae (GBS): CAMP test positive, causes neonatal meningitis and sepsis.
- Viridans streptococci: Optochin-resistant, cause dental caries (S. mutans) and SBE.
- Enterococci: Grow in 6.5% NaCl, bile esculin positive; cause UTIs, endocarditis. VRE is a major concern.
- S. bovis/gallolyticus complex: Associated with endocarditis and colon cancer.
Unlock the full lesson and continue reading
Signup to continue reading this lesson and unlimited access questions, flashcards, AI notes, and more